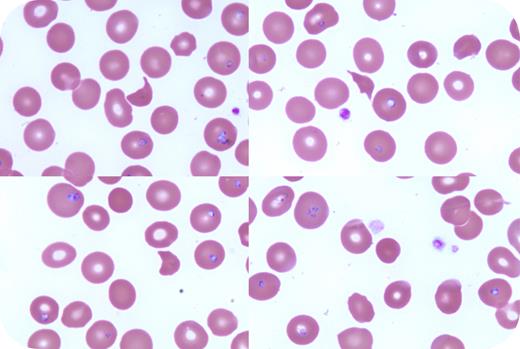
graphic

A healthy 75-year-old man presented with a 2-week history of fever, night sweats, weight loss, and diarrhea after returning from the Hudson River Valley, New York. He appeared icteric and investigations revealed a hemoglobin level of 78 g/L, platelet count of 89 × 109/L, lactate dehydrogenase level of 1483 U/L, total bilirubin level of 57 μmol/L, and undetectable haptoglobin levels. Peripheral blood smear demonstrated multiple pleomorphic intraerythrocytic ring forms and parasitemia at 17.1% (100× lens objective; Wright-Giemsa stain). Polymerase chain reaction confirmed infection with Babesia microti. The presence of hemolytic anemia with schistocytes and thrombocytopenia prompted investigations for concomitant thrombotic thrombocytopenic purpura (TTP). ADAMTS13 activity <10% and anti-ADAMTS13 activity of 51 U/mL confirmed TTP. The patient received azithromycin and atovaquone for babesiosis and daily plasma exchange therapy for TTP, whereas steroids were omitted due to active parasitic infection. He experienced resolution of symptoms and stabilization of hemoglobin and platelet values, with recovery of ADAMTS13 activity to 67% supporting a diagnosis of immune TTP (iTTP).
B microti is a tick-borne parasite endemic to the northeastern United States, with a growing incidence and geographic distribution. Although babesiosis can cause hemolytic anemia and thrombocytopenia, particularly in older or immunocompromised individuals, its presence should not preclude investigation for other causes such as thrombotic microangiopathy. To our knowledge, this is the first reported case of babesiosis precipitating iTTP, highlighting the importance of prompt smear review and combined management when overlapping conditions are identified.
For additional images, visit the ASH Image Bank, a reference and teaching tool that is continually updated with new atlas and case study images. For more information, visit https://imagebank.hematology.org.